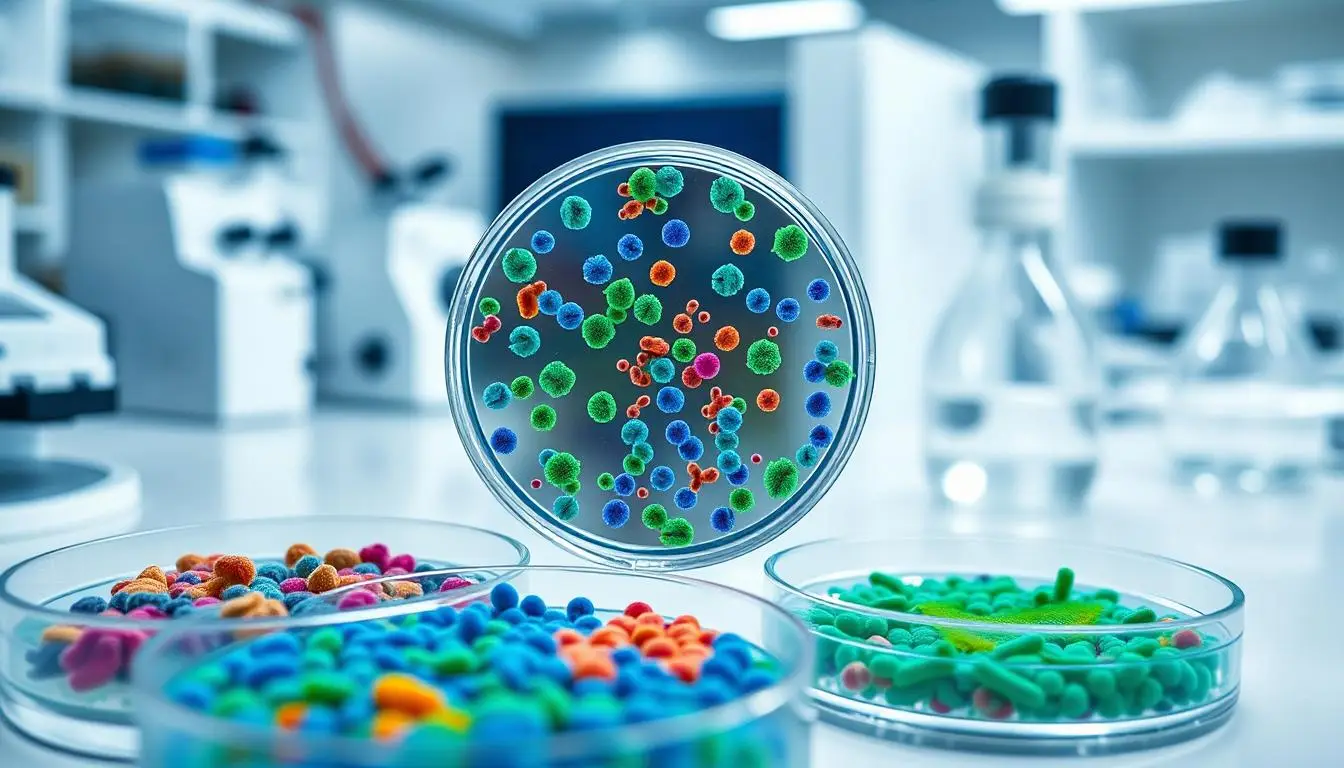

Die Welt der Medizin steht vor einer Darmflora-Revolution. Nach Jahren intensiver Forschung und klinischer Studien erreichen die ersten Microbiome-Therapeutika die Schwelle zur europäischen Zulassung. Diese bahnbrechenden Behandlungen nutzen die komplexe Ökologie unseres Darms, um Krankheiten zu bekämpfen – und öffnen damit ein völlig neues Kapitel in der Medizingeschichte. Was einst als Nischenforschung begann, entwickelt sich zu einem milliardenschweren Marktsegment mit dem Potenzial, Behandlungsstandards in der Onkologie und darüber hinaus grundlegend zu verändern.
Europas erste Microbiome-Therapie steht vor der Zulassung
MaaT Pharma schreibt Medizingeschichte: Das französische Biotech-Unternehmen hat die Marketingzulassung für sein Hauptprodukt MaaT013 (Handelsname Xervyteg®) bei der Europäischen Arzneimittelagentur eingereicht. Dieser Meilenstein markiert den Beginn einer neuen Ära in der europäischen Medizinlandschaft. Das Präparat zielt auf die Behandlung der akuten Graft-versus-Host-Erkrankung (aGvHD) ab – eine lebensbedrohliche Komplikation nach Stammzelltransplantationen, bei der das Spenderimmunsystem die Organe des Empfängers angreift.
Die Daten der entscheidenden Phase-III-Studie ARES sprechen eine klare Sprache: 62% der Patienten zeigten nach 28 Tagen ein Ansprechen im Magen-Darm-Trakt, und die 12-Monats-Überlebenswahrscheinlichkeit betrug 54% (vs. 15% in historischen Kontrollen). Für Patienten mit dieser schwerwiegenden Erkrankung, bei denen konventionelle Therapien versagen, könnte Xervyteg den dringend benötigten Durchbruch darstellen. Die Europäische Investitionsbank (EIB) hat das Potenzial erkannt und MaaT Pharma mit einer Finanzierungstranche von 37,5 Millionen Euro ausgestattet – ein deutliches Vertrauensvotum für die Zukunft der Mikrobiom-Medizin.
Die strategische Partnerschaft mit Clinigen, die eine Vorabzahlung von 10,5 Millionen Euro und bis zu 18 Millionen Euro potenzielle meilensteinbasierte Zahlungen umfasst, soll den Patientenzugang in ganz Europa beschleunigen. MaaT Pharma wird auch berechtigt sein, Lizenzgebühren sowohl für EAP-Behandlungen als auch für kommerzielle Nettoumsätze in Höhe eines mittleren zweistelligen Prozentsatzes zu erhalten. Diese finanziellen Erfolge, kombiniert mit steigenden Verkäufen im Early Access Program, spiegeln das wachsende Vertrauen der Investoren in diesen aufstrebenden Therapiebereich wider.
Die Wissenschaft hinter der Darmflora-Medizin
Microbiome-Therapeutika funktionieren nach einem grundlegend anderen Prinzip als klassische Medikamente. Statt einzelner Wirkstoffe setzen sie auf komplexe mikrobielle Ökosysteme, die das gestörte Gleichgewicht im Darm wiederherstellen. Präparate wie MaaT013 werden aus Spender-Mikrobiomen mit hoher bakterieller Diversität gewonnen und sollen die Darmhomöostase wiederherstellen. Präklinische und frühe klinische Studien zeigen, dass die Wiederherstellung der bakteriellen Vielfalt und die Produktion wichtiger Stoffwechselprodukte wie Butyrat dazu beitragen können, die Integrität der Darmschleimhaut zu verbessern und Immunantworten zu modulieren. Diese Wiederherstellung eines gesunden Darmökosystems kann systemische Entzündungsreaktionen dämpfen – ein entscheidender Faktor bei der Behandlung von immunvermittelten Erkrankungen wie aGvHD, bei der herkömmliche immunsuppressive Therapien oft an ihre Grenzen stoßen.
Von der Theorie zur klinischen Realität
Der Weg vom wissenschaftlichen Konzept zur anwendbaren Therapie war lang und herausfordernd. Jahrelange Grundlagenforschung war nötig, um die komplexen Wechselwirkungen zwischen Darmbakterien und menschlicher Gesundheit zu entschlüsseln. Die ersten Anwendungen beschränkten sich auf die Behandlung von wiederkehrenden Clostridium-difficile-Infektionen mittels Stuhltransplantationen – ein Verfahren, das zwar wirksam, aber schwer zu standardisieren war.
Der Durchbruch kam mit der Entwicklung standardisierter mikrobieller Präparate, die reproduzierbare Ergebnisse liefern können. MaaT Pharma hat diesen Ansatz perfektioniert und ein Verfahren entwickelt, das die Vielfalt und Funktionalität des Spendermikrobioms bewahrt, während es gleichzeitig höchste Sicherheitsstandards erfüllt.
Die positive Resonanz auf das Early Access Program (EAP) von MaaT013 unterstreicht das Sicherheitsprofil und die Wirksamkeit des Präparats. Dieses Programm ermöglicht Patienten mit lebensbedrohlichen Erkrankungen bereits vor der offiziellen Zulassung den Zugang zur Therapie – ein Zeichen für das Vertrauen der medizinischen Gemeinschaft in diesen innovativen Ansatz. Das Early Access Program umfasst mittlerweile 173 behandelte aGvHD-Patienten mit konsistenten Wirksamkeitsdaten.
Marktchancen und wirtschaftliche Perspektiven
Die wirtschaftlichen Aussichten für Mikrobiom-Therapeutika sind beeindruckend. Branchenanalysten prognostizieren ein rasantes Wachstum des Marktes in den kommenden Jahren. Die strategischen Partnerschaften und Finanzierungsrunden von MaaT Pharma sind ein deutliches Indiz für das kommerzielle Potenzial dieser neuen Therapieklasse.
Die Zusammenarbeit mit Clinigen – einschließlich einer Vorauszahlung von 10,5 Millionen Euro und potenzieller meilensteinbasierter Zahlungen – ist darauf ausgerichtet, den Patientenzugang in ganz Europa zu beschleunigen. Die zusätzliche Finanzierungstranche von 37,5 Millionen Euro durch die Europäische Investitionsbank verlängert die finanzielle Reichweite des Unternehmens bis Anfang 2026 und ermöglicht die Weiterentwicklung der Pipeline.
Regulatorische Meilensteine und ethische Überlegungen
Die europäischen Zulassungsbehörden stehen vor der Herausforderung, einen angemessenen Regulierungsrahmen für diese neuartige Therapieklasse zu schaffen. Die Europäische Arzneimittelagentur prüft derzeit den Zulassungsantrag von MaaT Pharma für MaaT013, was möglicherweise den Weg für das erste zugelassene Mikrobiom-Therapeutikum in Europa ebnen wird.
Neue regulatorische Ansätze – einschließlich Vorschlägen, mikrobiombasierte Therapien in die Definition biologischer Arzneimittel aufzunehmen – und die EU-Verordnung für Substanzen menschlichen Ursprungs (SoHO), die am 17. Juli 2024 veröffentlicht wurde und ab dem 7. August 2027 nach einer 3-jährigen Übergangszeit anwendbar sein wird, sollen die Zulassungen rationalisieren und die Harmonisierung zwischen den Mitgliedstaaten fördern. Die Microbiome Therapeutics Innovation Group (MTIG) weist auf Herausforderungen wie Spenderstandardisierung, Risikoanalysen und Qualitätskontrolle bei der Herstellung dieser komplexen Ökosysteme hin.
Die Verwendung von spenderbasierten Produkten wirft ethische Fragen zur Spenderauswahl und Pathogenübertragung auf. Obwohl die aktuellen Phase-III-Daten ein positives Nutzen-Risiko-Profil unterstützen, bestehen weiterhin Bedenken hinsichtlich der langfristigen Auswirkungen. Ethische Debatten drehen sich auch um die Sicherstellung einer informierten Einwilligung, da diese Therapien oft bei schwerkranken Patienten mit begrenzten Optionen eingesetzt werden.
Patientennutzen und medizinische Bedeutung
Für Patienten mit akuter GvHD, bei denen herkömmliche Behandlungen versagt haben, könnte MaaT013 einen entscheidenden Durchbruch darstellen. Die Erkrankung tritt bei etwa 50% der Patienten nach allogener Stammzelltransplantation auf und hat eine hohe Mortalitätsrate, insbesondere wenn der Magen-Darm-Trakt betroffen ist. Die Ansprechrate von 62% in der ARES-Studie gibt Hoffnung für eine Patientengruppe mit bislang sehr eingeschränkten Therapieoptionen.
Führende Experten auf dem Gebiet betonen das Potenzial von Mikrobiom-Therapeutika, klinische Lücken zu schließen, wo herkömmliche Behandlungen versagt haben. Die Fähigkeit, das Immunsystem zu modulieren, ohne es vollständig zu unterdrücken, könnte einen Paradigmenwechsel in der Behandlung immunvermittelter Erkrankungen einleiten.
Interviews in europäischen Fachmedien wie The Pharma Letter weisen darauf hin, dass mit zunehmender regulatorischer Klarheit Mikrobiom-Therapien nicht nur in der Hämato-Onkologie, sondern auch in der Immun-Onkologie und bei neurodegenerativen Erkrankungen Behandlungsparadigmen neu definieren könnten.
Die nächste Generation: Fortschritte in der Pipeline
Über MaaT013 hinaus entwickelt MaaT Pharma bereits die nächste Generation von Kandidaten wie MaaT033 und MaaT034, die auf rational gestalteten mikrobiellen Konsortien oder sogar spenderunabhängigen, ko-kultivierten Produkten basieren. Diese „spenderfreien“ Ansätze versuchen, die Produktzusammensetzung weiter zu standardisieren und könnten die Herstellungsprozesse vereinfachen.
MaaT033, das sich derzeit in einer Phase-2b-randomisierten kontrollierten Studie befindet, zielt darauf ab, das Gesamtüberleben nach allogener hämatopoetischer Stammzelltransplantation zu verbessern. Dieser oral verabreichte Kandidat könnte den Anwendungsbereich über die Behandlung bestehender Komplikationen hinaus auf die Prävention erweitern.
Parallel dazu eröffnen synthetische Biologie, Phagentherapie und CRISPR-basierte mikrobielle Genbearbeitung spannende neue Frontlinien. CRISPR-basierte mikrobielle Gentherapien haben in klinischen Studien die Fähigkeit demonstriert, antibiotikaresistente E. coli im Darm gezielt anzugreifen – ein vielversprechender Ansatz im Kampf gegen antimikrobielle Resistenzen.
Expandierende Indikationen: Von der Onkologie zur Neurologie
Während sich die ersten Zulassungen auf wiederkehrende C. difficile-Infektionen und aGvHD konzentrieren, werden bereits kardiovaskuläre, metabolische und neurologische Erkrankungen wie ALS und Parkinson erforscht. Klinische Studien erweitern den Anwendungsbereich von Mikrobiom-Interventionen von der Onkologie bis hin zu neurodegenerativen Erkrankungen.
Besonders vielversprechend erscheint die Anwendung bei Erkrankungen, bei denen eine Darm-Hirn-Achse vermutet wird. Präklinische Daten deuten darauf hin, dass bestimmte mikrobielle Metaboliten neuroprotektive Wirkungen entfalten können. Klinische Studien zu diesen Indikationen befinden sich noch in frühen Phasen, zeigen aber vielversprechende Signale.
Die Erweiterung des therapeutischen Spektrums könnte den Markt für Mikrobiom-Therapeutika exponentiell wachsen lassen.
Herausforderungen auf dem Weg zur breiten Anwendung
Trotz der vielversprechenden Fortschritte stehen Mikrobiom-Therapeutika noch vor erheblichen Herausforderungen. Die Komplexität dieser lebenden Arzneimittel stellt besondere Anforderungen an Herstellung, Qualitätskontrolle und Lagerung. Die Standardisierung von Spendermaterial bleibt eine Herausforderung, ebenso wie die Gewährleistung der Wirksamkeit über verschiedene Patientenpopulationen hinweg.
Die Kostenerstattung durch Gesundheitssysteme stellt eine weitere Hürde dar. Innovative Therapien wie Mikrobiom-Therapeutika erfordern oft neue Bewertungsmodelle, die über traditionelle pharmakoökonomische Ansätze hinausgehen. Gesundheitsökonomische Studien, die den langfristigen Nutzen und die potenziellen Kosteneinsparungen durch vermiedene Komplikationen berücksichtigen, werden entscheidend sein, um Kostenträger von der Wirtschaftlichkeit dieser Therapien zu überzeugen.
Auch das Verständnis der komplexen Wechselwirkungen zwischen Mikrobiom, Wirt und Erkrankung bleibt unvollständig. Die Identifizierung prädiktiver Biomarker für das Ansprechen auf die Therapie könnte dazu beitragen, die Patientenselektion zu verbessern und personalisierte Behandlungsstrategien zu entwickeln.
Geschäftsmodelle und Marktdynamik
Das Geschäftsmodell für Mikrobiom-Therapeutika entwickelt sich noch. Ein Ansatz besteht darin, spenderbasierten Produkten den Weg zu ebnen und gleichzeitig an der nächsten Generation synthetischer, vollständig definierter Konsortien zu arbeiten. Diese Strategie ermöglicht es Unternehmen, kurzfristige Einnahmen zu generieren und gleichzeitig langfristige Innovationen voranzutreiben.
Die Partnerschaft zwischen MaaT Pharma und Clinigen illustriert einen innovativen Ansatz zur Markteinführung: Während des Zulassungsverfahrens wird der Zugang über Early-Access-Programme ermöglicht, was wertvolle Erkenntnisse über die reale Anwendung liefert und gleichzeitig frühe Einnahmen generiert. Nach der Zulassung wird Clinigen die Vermarktung in Europa übernehmen, während MaaT Pharma sich auf die Weiterentwicklung seiner Pipeline konzentrieren kann.
Europäische Führungsrolle in der Mikrobiom-Medizin
Europa positioniert sich als führender Standort für die Entwicklung und Kommerzialisierung von Mikrobiom-Therapeutika. Die EU-Strategie zur Förderung der Mikrobiomforschung, wie sie von der Human Microbiome Action beschrieben wird, unterstreicht die wachsende Bedeutung dieses Feldes in der europäischen Gesundheitspolitik.
Regulatorische Entwicklungen, wie sie in einer Übersichtsarbeit in Nature Reviews von Julie Rodriguez und Kollegen dargestellt werden, zeigen, dass europäische Behörden proaktiv an der Schaffung eines förderlichen Umfelds für die Entwicklung und Zulassung von Mikrobiom-basierten Therapien arbeiten. Die EU-Verordnung für Substanzen menschlichen Ursprungs (SoHO) könnte einen harmonisierten Rahmen für die Verwendung von Spendermaterial in therapeutischen Produkten schaffen.
Diese regulatorische Klarheit, gepaart mit starker öffentlicher Forschungsförderung und einem robusten Biotechnologie-Ökosystem, könnte Europa einen Wettbewerbsvorteil in diesem aufstrebenden Sektor verschaffen. Die potenzielle Zulassung von MaaT013 würde diesen Vorsprung weiter festigen und könnte eine Welle von Investitionen und Innovationen im europäischen Biotech-Sektor auslösen.
Der Weg vom Labor zum Patienten: Wie Mikrobiom-Medizin die Behandlungspraxis verändert
Die Integration von Mikrobiom-Therapeutika in die klinische Praxis erfordert ein Umdenken in der medizinischen Gemeinschaft. Ärzte müssen sich mit einem völlig neuen Therapieansatz vertraut machen, der auf der Modulation komplexer mikrobieller Ökosysteme basiert, anstatt auf einzelnen Wirkstoffen. Fortbildungsprogramme und klinische Leitlinien werden entscheidend sein, um die Akzeptanz und korrekte Anwendung dieser innovativen Therapien zu fördern.
Interdisziplinäre Zusammenarbeit zwischen Gastroenterologen, Onkologen, Immunologen und Mikrobiologen wird zunehmend wichtig werden, um das volle Potenzial dieser Therapien auszuschöpfen. Die Etablierung spezialisierter Zentren für Mikrobiom-Medizin könnte dazu beitragen, Expertise zu bündeln und den Zugang zu diesen komplexen Therapien zu verbessern.
Patientenorganisationen spielen ebenfalls eine wichtige Rolle bei der Förderung des Bewusstseins und der Akzeptanz von Mikrobiom-Therapien. Ihre Beteiligung an der Gestaltung klinischer Studien und Zulassungsprozesse kann dazu beitragen, sicherzustellen, dass diese Innovationen den tatsächlichen Bedürfnissen der Patienten entsprechen.
Darm-Gesundheit als neuer Wirtschaftszweig
Die wachsende Anerkennung der zentralen Rolle des Mikrobioms für die menschliche Gesundheit hat bereits einen Boom im Verbrauchermarkt für Probiotika und präbiotische Produkte ausgelöst. Die Entwicklung verschreibungspflichtiger Mikrobiom-Therapeutika stellt die nächste Evolutionsstufe dar und eröffnet neue Geschäftsfelder für Biotech-Unternehmen, Pharmafirmen und Dienstleister.
Spezialisierte Dienstleister für Mikrobiom-Analysen, Biobanking von Spendermaterial und die Herstellung komplexer biologischer Produkte werden an Bedeutung gewinnen. Die Entwicklung neuer Technologien zur Charakterisierung und Manipulation des Mikrobioms schafft weitere Innovationsmöglichkeiten für Technologieunternehmen.
Gesundheitsdienstleister könnten spezialisierte Mikrobiom-Kliniken entwickeln, die personalisierte Diagnosen und Therapien anbieten. Die Integration von Mikrobiom-Analysen in die Präzisionsmedizin könnte einen neuen Standard in der personalisierten Gesundheitsversorgung setzen.
Vom Durchbruch zum Standard: Der Weg in die medizinische Zukunft
Die bevorstehende Zulassung der ersten Mikrobiom-Therapeutika in Europa markiert nicht das Ende, sondern den Anfang einer transformativen Reise in der Medizin. Mit jeder klinischen Studie, jeder Zulassung und jeder behandelten Patientin wächst unser Verständnis des komplexen Zusammenspiels zwischen Mikrobiom und menschlicher Gesundheit.
Während die erste Welle von Therapien auf spenderbasierten Ansätzen beruht, wird die nächste Generation wahrscheinlich präzisere, synthetisch hergestellte Konsortien umfassen, die auf spezifische Krankheitsmechanismen abzielen. Die Integration von Mikrobiom-Therapeutika mit anderen Modalitäten wie Immuntherapien könnte synergistische Effekte erzeugen und die Behandlungsergebnisse weiter verbessern.
Die wahre Revolution liegt jedoch in der grundlegenden Veränderung unserer Sichtweise auf Krankheit und Gesundheit. Das Mikrobiom lehrt uns, den menschlichen Körper als komplexes Ökosystem zu betrachten, in dem das Gleichgewicht zwischen verschiedenen Organismen und ihrem Wirt entscheidend für die Gesundheit ist. Diese ökologische Perspektive könnte zu einem Paradigmenwechsel in der Medizin führen – weg von der Bekämpfung einzelner Krankheitserreger hin zur Förderung gesunder mikrobieller Gemeinschaften.
Die Darmflora-Revolution: Mehr als nur eine neue Therapieform
Die Entwicklung von Mikrobiom-Therapeutika repräsentiert einen Wendepunkt in der Medizingeschichte. Zum ersten Mal werden komplexe mikrobielle Ökosysteme als Arzneimittel eingesetzt – ein Ansatz, der vor wenigen Jahrzehnten noch undenkbar schien. Diese Innovation öffnet nicht nur neue Behandlungsmöglichkeiten für schwerwiegende Erkrankungen, sondern verändert auch grundlegend unser Verständnis von Gesundheit und Krankheit.
Mit der bevorstehenden europäischen Zulassung von MaaT013 und einer Pipeline vielversprechender Kandidaten steht die Mikrobiom-Medizin an der Schwelle zum klinischen Mainstream. Für Patienten, Ärzte, Forscher und Unternehmen bietet diese Entwicklung spannende Perspektiven – von verbesserten Behandlungsergebnissen über wissenschaftliche Durchbrüche bis hin zu neuen Geschäftsmöglichkeiten.
Die Darmflora-Revolution hat gerade erst begonnen, und ihre Auswirkungen werden weit über die aktuellen Anwendungsgebiete hinausreichen. In einer Zeit, in der antimikrobielle Resistenzen zunehmen und chronische Erkrankungen eine wachsende Belastung darstellen, könnte dieser ökologische Ansatz zur Wiederherstellung mikrobieller Gleichgewichte einen dringend benötigten Paradigmenwechsel in der Medizin einleiten.
maatpharma.com – September 17, 2025: MaaT Pharma Publishes its Half Year 2025 Results and Provides a Business Update
thepharmaletter.com – MaaT closes in on Europe’s first microbiota therapeutic approval
microbiometig.org – MTIG Statements
humanmicrobiomeaction.eu – Microbiomes move from the margins to the mainstream in EU strategy
nature.com – The regulatory framework for microbiome-based therapies: insights into European regulatory developments (Julie Rodriguez et al.)
europeanpharmaceuticalreview.com – CRISPR-based microbial gene therapy delivers promise
live.euronext.com – MaaT Pharma Presents Updated Positive Data in Early Access Program for Xervyteg® at the EHA Congress
maatpharma.com – January 8, 2025: MaaT Pharma Announces Positive Topline Results from the Pivotal Phase 3 ARES Study
maatpharma.com – June 2, 2025: MaaT Pharma Advances Toward Commercialization
maatpharma.com – July 2nd, 2025: MaaT Pharma Announces Exclusive Commercialization Partnership With Clinigen
maatpharma.com – July 28, 2025: MaaT Pharma Secures €37.5 Million Loan From European Investment Bank (EIB)